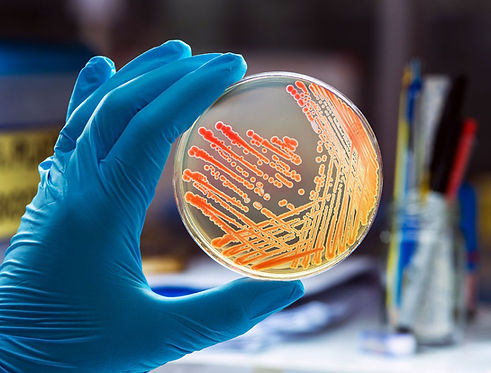

MORE ON OUR SERVICES

Asbestos
Asbestos is a natural fiber formerly used in many building materials; when disturbed, its airborne fibers are carcinogenic and pose serious health risks if inhaled.
-
Asbestos Surveys
Comprehensive pre-renovation or demolition inspections to identify the presence of asbestos, with sampling and lab analysis in compliance with AHERA, Cal/OSHA, and SDAPCD regulations.
-
Onsite PCM Air Clearance Testing
Same-day air monitoring post-abatement using PCM to verify airborne fiber concentrations are below re-occupancy levels.
-
TEM Air Clearance Sampling
High-sensitivity air testing using TEM, required for certain school and residential clearances under EPA/AHERA.
-
Contamination Assessments
Assessment of asbestos dust or debris after damage or improper disturbance, with sampling and risk evaluation.
-
Emergency Response Services
24/7 response for urgent asbestos issues, including damage, construction delays, or unexpected exposure concerns.
Mold & Moisture
Assessment and testing of indoor environments to detect mold growth, moisture intrusion, and related health risks—helping ensure safe, dry, and healthy spaces.
-
Initial Mold Assessments
Thorough inspections to identify visible mold, moisture sources, and hidden growth.Includes air or surface sampling and recommendations.
-
Post-Remediation Mold Clearances
Verification testing to confirm remediation was successful and the space is safe for re-occupancy. Includes visual inspection and air sampling as needed.
-
Contents Testing
Assessment of personal items (furniture, clothing,, etc.) for mold contamination to determine if cleaning, disposal, or specialized treatment is needed.
-
Indoor Allergen Sampling
Dust sampling to detect common indoor allergens such as mold spores, dust mites, pet dander, and pollen—useful in evaluating occupant exposure and indoor environmental quality.
-
Occupant Health Complaints
Environmental assessments in response to symptoms like respiratory issues, fatigue, or headaches, often linked to mold, allergens, or poor indoor air quality.


Lead
Lead is a toxic metal once commonly used in paint, plumbing, and other building materials. Exposure—especially through dust, soil, or drinking water—can harm the brain and nervous system, particularly in children and pregnant women.
-
XRF Lead-Based Paint Inspections
Fast, non-destructive testing using X-ray fluorescence (XRF) to detect lead-based paint in residential, commercial, and institutional buildings—performed in compliance with HUD and EPA standards.
-
Lead Dust Clearance Testing
Post-abatement or post-renovation dust wipe sampling to verify safe reoccupancy and compliance with HUD/EPA clearance levels.
-
Lead in Soil Analysis
Soil sampling and analysis to assess potential lead contamination around buildings, playgrounds, and bare yard areas—often required for child-occupied facilities or pre-construction due diligence.
-
Lead-in-Water Testing for Licensed Child Care Centers (CCCs)
Compliance sampling of potable water outlets in licensed childcare centers as required by California regulations. Includes coordination with ELAP-accredited labs and detailed reporting.
Indoor Air Quality
Assessment and testing of indoor environments to detect mold growth, moisture intrusion, and related health risks—helping ensure safe, dry, and healthy spaces.
-
Initial Mold Assessments
Thorough inspections to identify visible mold, moisture sources, and hidden growth.Includes air or surface sampling and recommendations.
-
Post-Remediation Mold Clearances
Verification testing to confirm remediation was successful and the space is safe for re-occupancy. Includes visual inspection and air sampling as needed.
-
Contents Testing
Assessment of personal items (furniture, clothing,, etc.) for mold contamination to determine if cleaning, disposal, or specialized treatment is needed.
-
Indoor Allergen Sampling
Dust sampling to detect common indoor allergens such as mold spores, dust mites, pet dander, and pollen—useful in evaluating occupant exposure and indoor environmental quality.
-
Occupant Health Complaints
Environmental assessments in response to symptoms like respiratory issues, fatigue, or headaches, often linked to mold, allergens, or poor indoor air quality.


Volatile Organic Compounds
Volatile Organic Compounds (VOCs) are airborne chemicals emitted from sources like paints, cleaners, adhesives, building materials, and personal care products. They can affect indoor air quality and pose significant health risks, ranging from irritation and headaches to serious conditions; some VOCs are carcinogenic.
-
Comprehensive VOC Air Sampling with EPA Method TO-15
We perform air sampling for 74 VOCs using SUMMA canisters analyzed with EPA’s TO-15 method. This widely recognizedadvanced technique detects harmful chemicals from sources such as fossil fuels, smoking, paints, adhesives, cleaning products, building materials, personal care items, and vehicle exhaust. Results are compared to health-based exposure limits (Cal/OSHA, EPA, CA OEHHA) to assess odors, indoor air quality, and potential health risks. This service is ideal for residential, commercial, healthcare, and industrial settings.
The process involves collecting air samples in a stainless steel canister, which is sealed and sent to a laboratory for analysis. Using gas chromatography-mass spectrometry (GC/MS), the lab separates and identifies individual VOCs, quantifying each compound by comparison to calibrated standards.
Bacteria
Bacteria are microscopic organisms found throughout our environment—some harmless, others harmful. After black water (Category 3) events involving sewage or floodwaters, dangerous bacteria like E. coli and fecal coliforms may be present. Testing helps assess contamination, verify cleanup, and ensure spaces are safe for use.
.
-
Initial Bacteria Assessments
Pre-remediation evaluation to determine the presence and extent of bacterial contamination in affected materials and surfaces. -
Post-Remediation Clearance Testing
Final testing to confirm that bacterial levels have been reduced to safe or non-detectable levels following cleanup. -
Fecal Coliform, Total Coliform, and E. Coli Detection (Presence/Absence)
Targeted microbial testing for indicators of fecal contamination using culture-based or molecular methods. -
ATP (Adenosine Triphosphate) Cleaning Verification
Rapid post-cleaning assessment using ATP meters to detect organic matter, helping confirm effective sanitation. -
Quantitative & Qualitative Results
Clear reporting with either presence/absence results or quantified data (e.g., CFU/cm² or MPN counts) for documentation and compliance purposes.

Sulfur Gases
We provide specialized air sampling and analysis for sulfur-based gases that may be responsible for strong odors or potential health effects in indoor environments.
-
Passive Monitoring with SUMMA Canisters – ASTM D5504-12
Using ASTM D5504-12, a sensitive analytical method, we perform air sampling with SUMMA canisters to detect and quantify sulfur-based gases such as:
- Hydrogen sulfide (H₂S) – commonly linked to “rotten egg” odors and sewer gas
- Carbon disulfide (CS₂) – present in some industrial emissions and contaminated indoor air
- Methyl mercaptan (CH₄S) – a strong-smelling compound associated with waste and decomposition
Results are evaluated against occupational (OSHA, ACGIH) and environmental exposure limits to identify potential odor sources and assess health risks.
Suitable for residential, commercial, and industrial applications.
Respirator Fit Testing
Ensure your team’s safety and regulatory compliance with our professional respirator fit testing services. We provide qualitative fit testing in accordance with OSHA 29 CFR 1910.134 and all applicable federal, state, and local regulations.
.
-
Qualitative Fit Testing – California Compliance
Cal-OSHA-compliant qualitative fit testing for N95, P100 half-face, and full-face respirators using approved test agents (Bitrex or Saccharin). This method assesses the respirator’s seal by evaluating the wearer’s ability to detect the test agent under a controlled protocol.
Our service includes:
-
Testing conducted by trained professionals
-
Use of OSHA-approved protocols per 29 CFR 1910.134 Appendix A
-
General awareness training on respirator use and maintenance
-
Documentation of results and fit test records for your compliance files
-
Suitable for companies with 1 to 100 employees
Ideal for construction, healthcare, restoration, and other industries requiring respiratory protection.
We service clients across California, both on-site and at our testing locations.


Smoke & Soot Assessments
We provide comprehensive evaluations of properties impacted by fire, smoke, and soot residues to determine the extent of contamination and guide proper remediation.
-
Residential & Commercial Impact Assessments
Detailed onsite evaluations to assess smoke and soot damage across structures and surfaces, helping determine restoration scope and material salvageability. -
Contents Contamination Assessments
Evaluation of personal property and building contents (furniture, electronics, textiles, etc.) to identify smoke, soot, or char contamination and recommend cleaning, restoration, or disposal. -
Cleaning & Mitigation Work Plans
Customized work plans outlining required cleaning protocols, methods, and materials based on the extent of damage, surface types, and restoration goals. Designed to meet insurance and regulatory standards. -
PLM & SEM Sampling for Soot and Char Analysis
Advanced laboratory analysis using Polarized Light Microscopy (PLM) and Scanning Electron Microscopy (SEM) to confirm presence and type of combustion residues, supporting insurance claims and remediation decisions.
CONTACT US
Let Air Check Solutions do the work for you. Please give us a call at (858) 926-9906 or complete the contact form below.